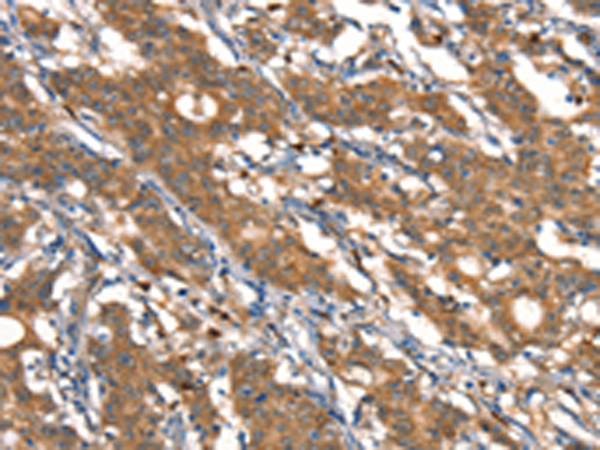

-
分类: 科研抗体货号: P11682别名: CRF2; CRFR2; CRF-RB; HM-CRF应用: WB,IHC反应种属: Human, Mouse, Rat
-
分类: 科研抗体货号: P11683别名: S52; CRIM-1应用: IHC反应种属: Human, Mouse
-
分类: 科研抗体货号: P11699别名: MTCYB; CYTB应用: IHC反应种属: Human
-
分类: 科研抗体货号: P11680别名: KN; C3BR; C4BR; CD35应用: IHC反应种属: Human
-
分类: 科研抗体货号: P11698别名: PME; ULD; CST6; EPM1; STFB; EPM1A应用: WB,IHC反应种属: Human, Mouse
-
分类: 科研抗体货号: P11710别名: HP4; DEF4; HP-4; HNP-4应用: IHC反应种属: Human
-
分类: 科研抗体货号: P11723别名: DNL; DNL2; DNASE2A应用: WB反应种属: Human
-
分类: 科研抗体货号: P11709别名: CLEC4N; CLECSF10应用: IHC反应种属: Human
-
分类: 科研抗体货号: P11722别名: HYRC; p350; DNAPK; DNPK1; HYRC1; IMD26; XRCC7; DNA-PKcs应用: WB,IHC反应种属: Human, Mouse
-
分类: 科研抗体货号: P11708别名: DECR; NADPH; SDR18C1应用: WB,IHC反应种属: Human, Mouse, Rat

鄂公网安备42018502007531号
鄂公网安备42018502007531号

